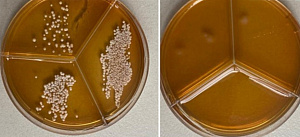
Томские ученые создали антимикробную упаковку для продуктов

По оценкам ученых, новая полипропиленовая пленка, модифицированная двухкомпонентными наночастицами оксида цинка и серебра (ZnO/Ag), способна эффективно подавлять рост патогенных бактерий и грибков на своей поверхности, уничтожая практически 100 % микроорганизмов. Это позволит значительно увеличить срок годности продуктов и снизить риск пищевых отравлений. Аналогов такой упаковки на отечественном рынке пока нет.
По оценкам ученых, новая полипропиленовая пленка, модифицированная двухкомпонентными наночастицами оксида цинка и серебра (ZnO/Ag), способна эффективно подавлять рост патогенных бактерий и грибков на своей поверхности, уничтожая практически 100 % микроорганизмов. Это позволит значительно увеличить срок годности продуктов и снизить риск пищевых отравлений. Аналогов такой упаковки на отечественном рынке пока нет.Полимерные материалы, такие как полипропилен, идеальны для упаковки: они прочные, гибкие, дешевые и надежно защищают продукты от влаги и кислорода. Однако у них есть серьезный недостаток — на поверхности обычного пластика бактерии могут выживать неделями, что сокращает срок годности продуктов и создает риски для потребителей.
Читать материал подробнее

